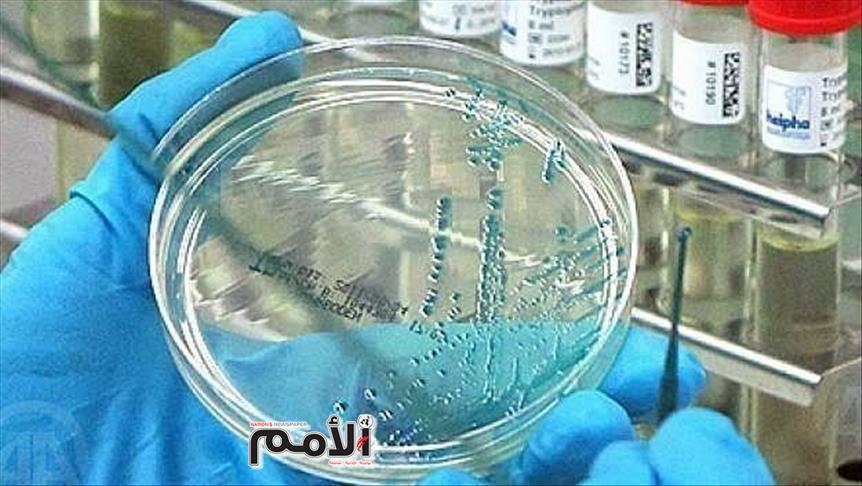

قال إعلام عبري إن “إسرائيليا” عائدا من الصين جرى نقله، مساء السبت، إلى المستشفى للاشتباه في إصابته بفيروس “كورونا” الجديد المتفشي في مدينة ووهان الصينية.
وقالت صحيفة “يديعوت أحرنوت”، عبر موقعها الإلكتروني، إنه تم إدخال “إسرائيلي” عائد من الصين إلى مستشفى “تل هشومير” في منطقة “غوش دان” قرب تل أبيب، وسط البلاد؛ إثر الاشتباه في إصابته بفيروس “كورونا”.
من جانبها، أوصت وزارة الصحة “الإسرائيلية”، اليوم، بعدم التوجه أو السفر إلى “ووهان” الصينية مصدر تفشي وباء “كورونا”.
وحسب قناة “كان” العبرية (رسمية)، أكدت الوزارة أنها على تواصل مع الجهات الدولية ذات العلاقة، وستطلع الجمهور عن آخر المستجدات بهذا الشأن.
وفي وقت سابق اليوم، أعلنت اللجنة الطبية الوطنية في الصين بأن 41 شخصا لقوا مصرعهم حتى الآن جراء الفيروس، بينما وصل عدد المصابين إلى ألف و287 شخصا، 237 منهم في حالة خطرة.
وفيروس “كورونا” الجديد الذي بات يسمى بـ”فيروس ووهان” نظرا لاكتشاف أول حالة إصابة بالفيروس بهذه المدينة، ينتقل عن طريق الجو عبر التنفس والعطس والسعال.
وأول أعراض الإصابة بالفيروس، ارتفاع درجة حرارة الجسم، وألم في الحنجرة، والسعال، وضيق في التنفس، والإسهال، وفي المراحل المتقدمة يتحول إلى التهاب رئوي، وفشل في الكلى قد ينتهي بالموت.